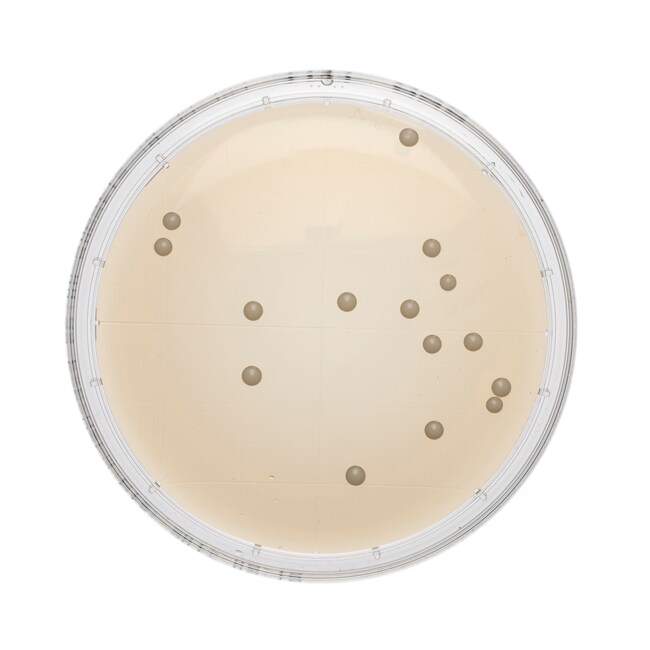
Sabouraud Dextrose Agar Irradiated (Triple Wrap) Plate

Search
Search
Experience next-level cleanroom confidence with Thermo Scientific™ Oxoid™ Sabouraud Dextrose Agar Plate. The Sabouraud Dextrose Agar supports the growth of yeasts, fungi and molds.
Perform effortless environmental monitoring with Tryptone Soya Agar Irradiated (Triple Wrap) Plate.
Not all products are available for sale in all territories. Please inquire.
Remel™ and Oxoid™ products are now part of the Thermo Scientific brand.